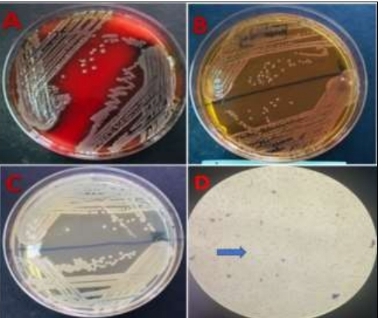
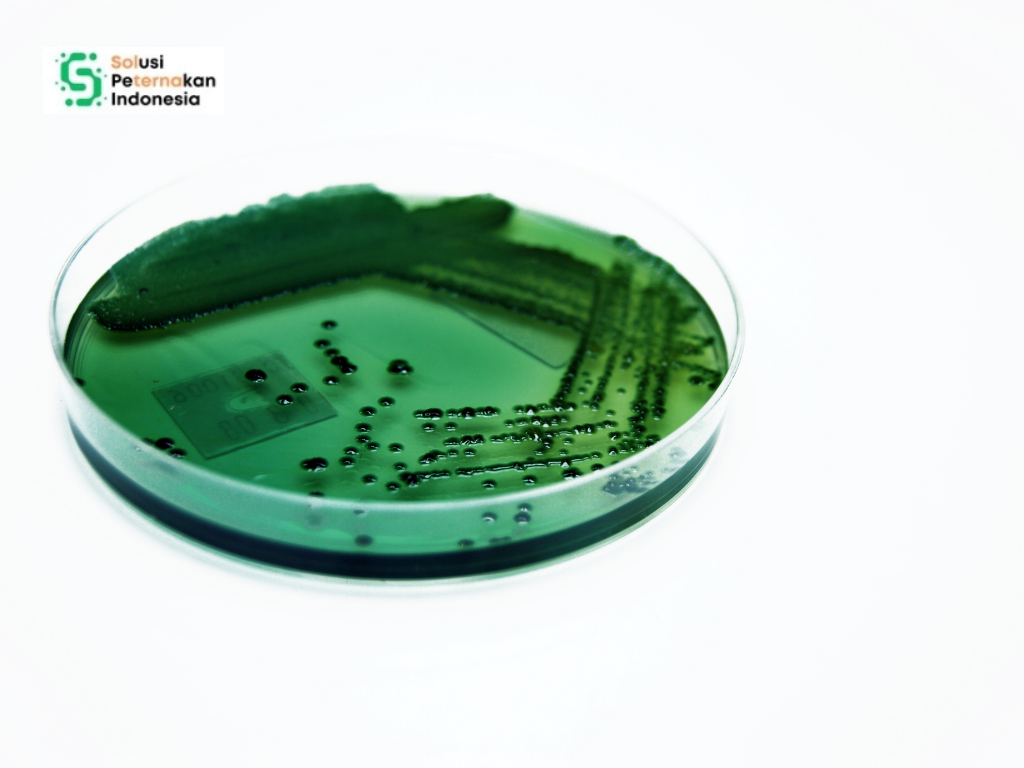

Bagi banyak negara berkembang, termasuk Kenya, akuakultur atau budidaya ikan bukan sekadar bisnis, melainkan sumber pangan utama sekaligus penghidupan masyarakat pedesaan. Ikan seperti nila, lele, dan bahkan ikan hias memberikan protein berkualitas tinggi bagi keluarga, sekaligus pemasukan ekonomi dari pasar lokal hingga ekspor. Namun, keberlanjutan usaha ini sering terancam oleh satu musuh tak terlihat: penyakit bakteri.
Salah satu penyakit yang paling meresahkan adalah yang disebabkan oleh bakteri dari genus Aeromonas. Bakteri ini dikenal oportunis, artinya bisa hidup tenang di lingkungan, tetapi jika kondisi ikan melemah, ia akan berubah menjadi “pembunuh” mematikan.
Penelitian terbaru di Kenya menyingkap kasus kematian massal ikan yang dikaitkan dengan bakteri Aeromonas. Hasil studi ini bukan hanya penting bagi petani ikan Kenya, tapi juga memberi peringatan bagi seluruh pelaku akuakultur dunia.
Kisahnya bermula di sebuah peternakan ikan di Narok County, Kenya. Para petani dikejutkan oleh kematian mendadak ribuan ikan, mulai dari nila, lele, hingga ikan hias. Kerugian ekonomi pun sangat besar: bukan hanya kehilangan stok ikan siap panen, tetapi juga hilangnya kepercayaan pasar terhadap produk mereka.
Untuk mencari penyebabnya, para peneliti dari University of Nairobi turun tangan. Mereka mengumpulkan sampel air dari kolam menggunakan botol steril, lalu membawanya ke laboratorium untuk dianalisis. Fokus mereka: mencari keberadaan bakteri penyebab penyakit.
Baca juga artikel tentang: Airborne Transmission: Puzzle Baru Penyebaran Flu Burung di Peternakan
Menemukan Tersangka: Aeromonas
Dengan serangkaian uji laboratorium, mulai dari kultur bakteri, uji biokimia, hingga teknologi canggih MALDI-TOF (Matrix Assisted Laser Desorption/Ionization Time of Flight) dan Whole Genome Sequencing para peneliti berhasil mengidentifikasi tersangka utama: Aeromonas veronii, lebih spesifik lagi strain bernama biovar Sobria.
Bakteri Aeromonas dikenal luas di dunia akuakultur. Ia hidup di air tawar, terutama yang kualitasnya menurun akibat kepadatan ikan terlalu tinggi atau kebersihan kolam kurang terjaga. Begitu ikan stres, misalnya karena kekurangan oksigen atau perubahan suhu, Aeromonas dengan cepat menyerang. Gejalanya bisa berupa pendarahan pada kulit, luka bernanah, hingga kerusakan organ dalam.
Petunjuk dari Genom
Yang menarik, analisis genom bakteri tersebut menunjukkan ukurannya sekitar 4,6 juta pasang basa dengan kandungan GC sekitar 59%, ciri khas yang bisa digunakan untuk membedakan strain. Lebih mengejutkan lagi, pohon kekerabatan (phylogenetic analysis) mengungkap bahwa strain ini mirip dengan isolat Aeromonas yang ditemukan pada ikan di Asia dan Amerika Selatan, bahkan juga mirip dengan isolat yang pernah menyerang manusia di Asia dan Australia.
Artinya, bakteri ini punya daya sebar global. Bisa jadi terbawa melalui perdagangan ikan, air, atau bahkan melalui interaksi manusia. Ini menegaskan bahwa masalah penyakit ikan bukan hanya lokal, tapi bersifat internasional.
Dampak Besar bagi Peternak
Bagi petani ikan di Kenya, wabah ini jelas menghancurkan. Ikan yang mati bukan hanya berarti kerugian modal, tapi juga berkurangnya pasokan pangan masyarakat. Ingat, ikan adalah salah satu sumber protein paling terjangkau di banyak daerah pedesaan. Jika produksi ikan menurun, otomatis harga naik dan keluarga miskin paling terdampak.
Lebih jauh lagi, penyakit ikan dapat membuat petani kehilangan semangat untuk terus berusaha. Beberapa bahkan bisa gulung tikar. Karena itu, memahami penyebab dan pencegahan penyakit seperti Aeromonas sangat penting agar sektor akuakultur tetap berkelanjutan.
Mengapa Aeromonas Berbahaya?
Ada beberapa alasan kenapa Aeromonas sangat ditakuti dalam dunia perikanan:
- Mudah Menyebar
Hidup alami di air, sehingga hampir mustahil dihilangkan sepenuhnya. - Menyerang Saat Ikan Stres
Perubahan suhu, kualitas air buruk, atau kepadatan ikan tinggi bisa memicu wabah. - Bersifat Zoonosis
Beberapa strain Aeromonas dapat menginfeksi manusia, terutama yang memiliki luka terbuka atau sistem imun lemah. Jadi, petani ikan juga berisiko. - Sulit Dikendalikan dengan Antibiotik
Penggunaan antibiotik sembarangan bisa menyebabkan resistensi, membuat pengobatan makin sulit.
Apa yang Bisa Dilakukan?
Hasil studi ini menekankan bahwa kita tidak bisa hanya bereaksi setelah wabah terjadi. Perlu langkah pencegahan berlapis:
- Manajemen Kualitas Air: memastikan oksigen cukup, mengurangi limbah organik, dan menjaga kepadatan ikan ideal.
- Higienitas Kolam: pembersihan rutin dan pencegahan kontaminasi dari luar.
- Pemantauan Rutin: sampling air dan ikan secara berkala agar tanda awal penyakit bisa terdeteksi.
- Vaksinasi: peneliti menyoroti perlunya pengembangan vaksin autogen (vaksin yang dibuat dari strain lokal spesifik) untuk mencegah wabah berulang.
- Edukasi Petani: memberi pengetahuan dasar tentang biosekuriti dan pencegahan penyakit.
Pesan untuk Dunia
Penelitian ini bukan hanya cerita lokal Kenya, melainkan cermin bagi negara lain. Dalam era globalisasi, penyakit ikan bisa melintas benua dalam hitungan hari. Kasus Aeromonas di Kenya yang mirip dengan isolat Asia dan Amerika Selatan membuktikan hal itu.
Maka, kerja sama internasional sangat dibutuhkan, mulai dari pertukaran data penyakit, penelitian bersama, hingga regulasi perdagangan ikan yang lebih ketat. Dengan begitu, ancaman global bisa diminimalkan.
Kematian massal ikan di Kenya akibat bakteri Aeromonas veronii adalah peringatan keras bagi dunia akuakultur. Ia menunjukkan betapa rapuhnya sistem produksi pangan jika tidak disertai pengawasan kesehatan ikan yang baik.
Namun, kabar baiknya, ilmu pengetahuan memberi kita alat untuk melawan. Dengan teknologi modern seperti whole genome sequencing, kita bisa mengenal musuh hingga ke tingkat DNA. Pengetahuan ini membuka jalan bagi pengembangan vaksin dan strategi pencegahan yang lebih efektif.
Bagi petani ikan, pelajaran utamanya jelas: menjaga kesehatan ikan sama pentingnya dengan memberi pakan atau merawat kolam. Sebab, tanpa ikan yang sehat, semua usaha bisa lenyap hanya dalam semalam.
Baca juga artikel tentang: Probiotik dan Herbal, Duo Ajaib Penjaga Kesehatan Ikan Mas
REFERENSI:
Ndegwa, Joseph M dkk. 2025. Conventional and molecular characterization of an Aeromonas isolate recovered from an aquaculture farm with high fish mortality in Kenya. International Journal of Fisheries and Aquatic Studies 13 (1), 01-09.